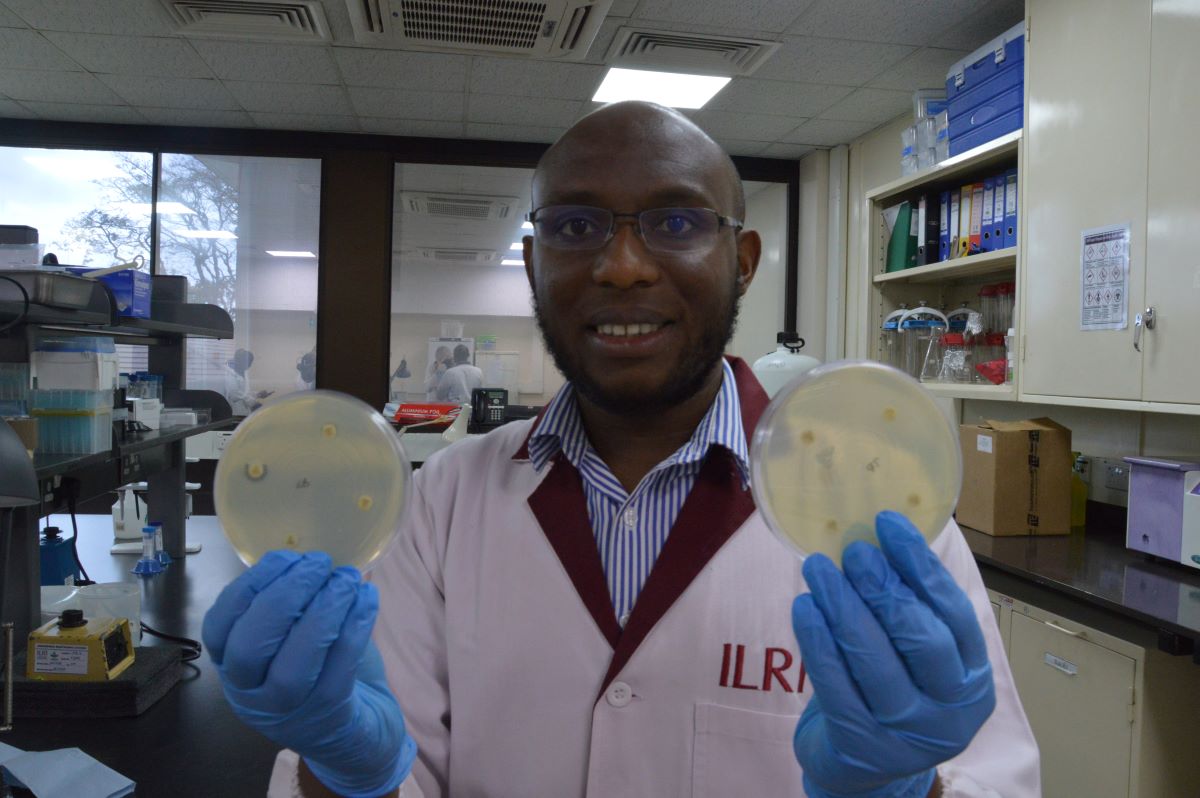
På <a href="/ILRI/">ILRI.org</a> -labbet i Nairobi visar forskaren <a href="/dishonmuloi/">Dishon Muloi</a> upp prover med resistenta bakterier. Antibiotika används inom djuruppfödning utan restriktioner och ofta i förebyggande syfte helt i onödan. <a href="/Sida/">Sida</a> forskningssamarbete motverkar #AMR

Kerstin J Cisse
@cissekerstin
Head of Unit for Research Cooperation, Sida. Follows international cooperation and communication.
ID: 2942477385
26-12-2014 18:39:37
564 Tweet
618 Takipçi
344 Takip Edilen

Kom till Järvaveckan den 2-3 juni på Spånga IP! Där kan du träffa oss på Sida höra mer om Den globala skolan, prata bistånd och globala livsmedelssystem jarvaveckan.se/utstallare/sia… SIANI WWF Sweden Youth


Introduced by Helen Eduards and @AnnikaSunden, the World Bank’s Co-Director of the World Development Report, Xavier Devictor, presented this year’s report and how countries better can manage migration, in a seminar hosted by @EBACommittee, @Delmigram & Sida. sida.se/seminarier-och…






A RECAP about the strong impact made by our Program to University of Rwanda by Amb. Dr Charles Murigande. Over 20 years, the bilateral partnership significantly contributed to the development of #Rwanda through a pool of researchers & leaders now in the country’s decision making positions





Building of 20+ years of strengthening of research capacity and higher education the back bone in development Barni Nor Johan Sävström stefan swartling peterson






A pleasure to take part of all the life saving results that have been produced over the 50 years. Research on diseases of poverty! MFogde maytebejarano Marie Ottosson Jakob Granit

Today, Sweden 🇸🇪 signed an agreement with UNDP Liberia and the Government of Liberia 🇱🇷 to support the National Development Planning Process. By the agreement signed today, Sweden will provide 4 million SEK towards the process.